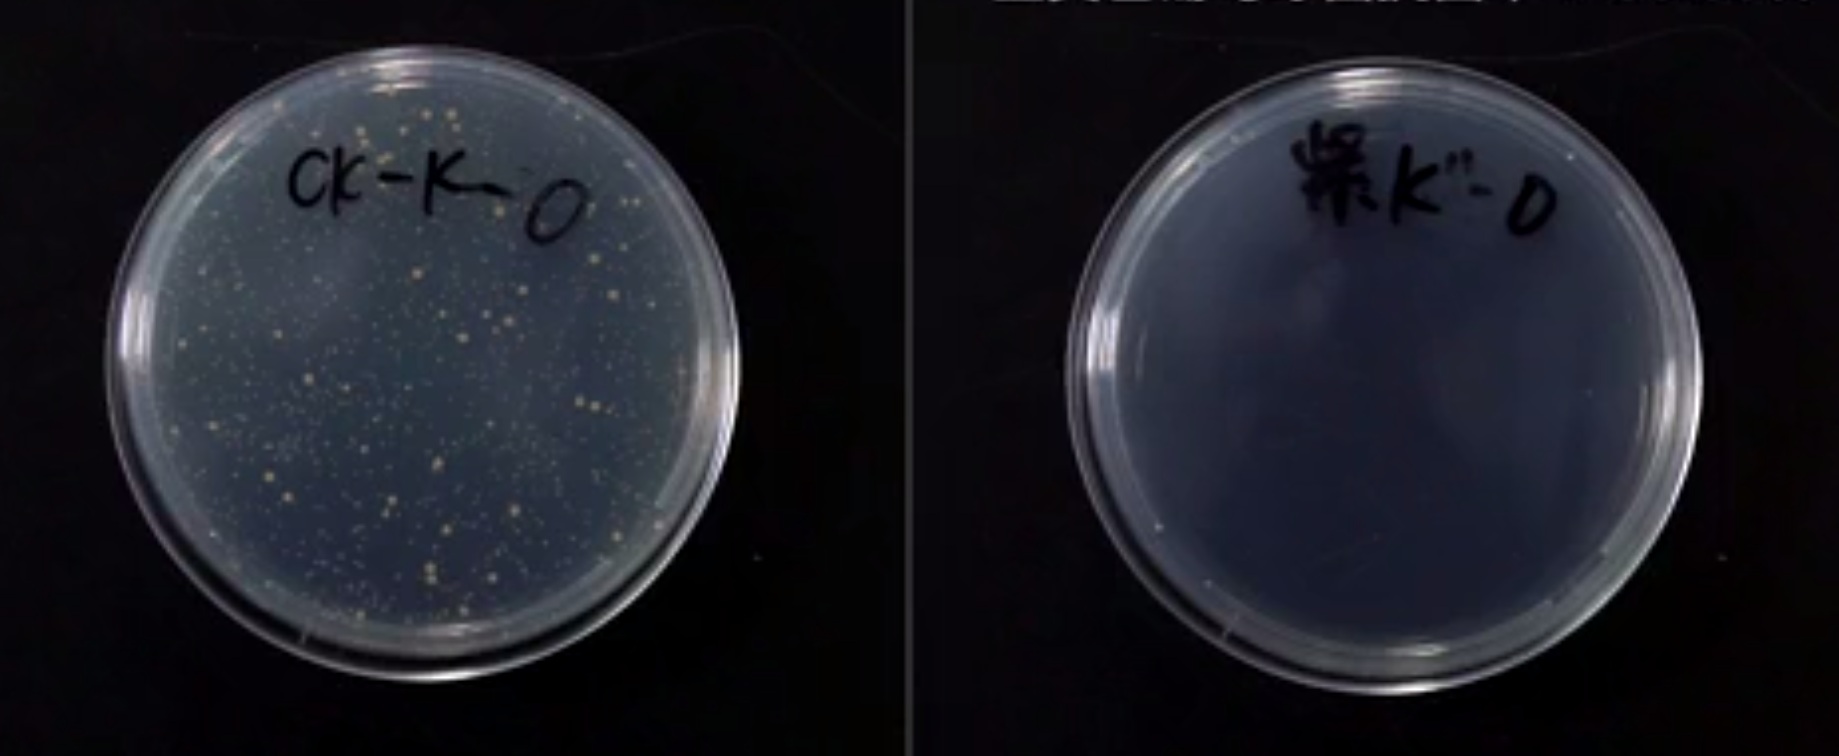

New Antibacterial Filter for the Mi Air Purifier Works Wonders
- 19.07.2017
- 615
- Joney Tour
- Add new comment
We get used to new technologies pretty quickly and then start taking most of those conveniences for granted. For example, when was the last time you turned on Xiaomi Mi Air Purifier saying: “Wow! I will breathe clean air! That is amazing! I should make a post on Facebook or Instagram about that.” Probably never.
It is sometimes sad to realize that we spend our lives using extraordinary technologies without acknowledging how big of a difference they actually make, Mi Air Purifier in particular. In this article, we will review its latest update, but before that, we would like to mention some of the health threatening airborne pollutants that live in our houses:

- pets’ odors and hairs cause allergies that can result in a visit to the hospital;
- mould spores, which develop in humid areas of your house like bathrooms, can cause lung infections;
- dust mites that breed in the dust in your house cause allergies;
- some of the cooking odors that are difficult to get rid of can be very unpleasant and make it hard to breathe;
- cigarette smoke inhalation can cause lung cancer in non-smokers etc.
A new antibacterial filter for the Mi Air Purifier has been made to eliminate those nasty allergens from your home and prevent you from getting sick. However, filtration is not the only function of the filter. It also works as a sterilizer and disinfects the air from bacteria and odors. The use of this antibacterial filter is especially important in the spring or in the summer when bacteria multiply at the harmful level.

In order to confirm the high quality and efficiency of the new filter, Xiaomi conducted a medical experiment. The results of this experiment were amazing: the use of the filter suppressed the growth of bacteria by 99.99%! That’s what we call real air purification!
Mi Air Purifiers combines air cleaning and sterilizing technologies that will help you say goodbye to allergy causing pollutants and bacteria and enjoy breathing clean air!
Want to see how the inside of the filter looks after a month of usage, check out this article.
